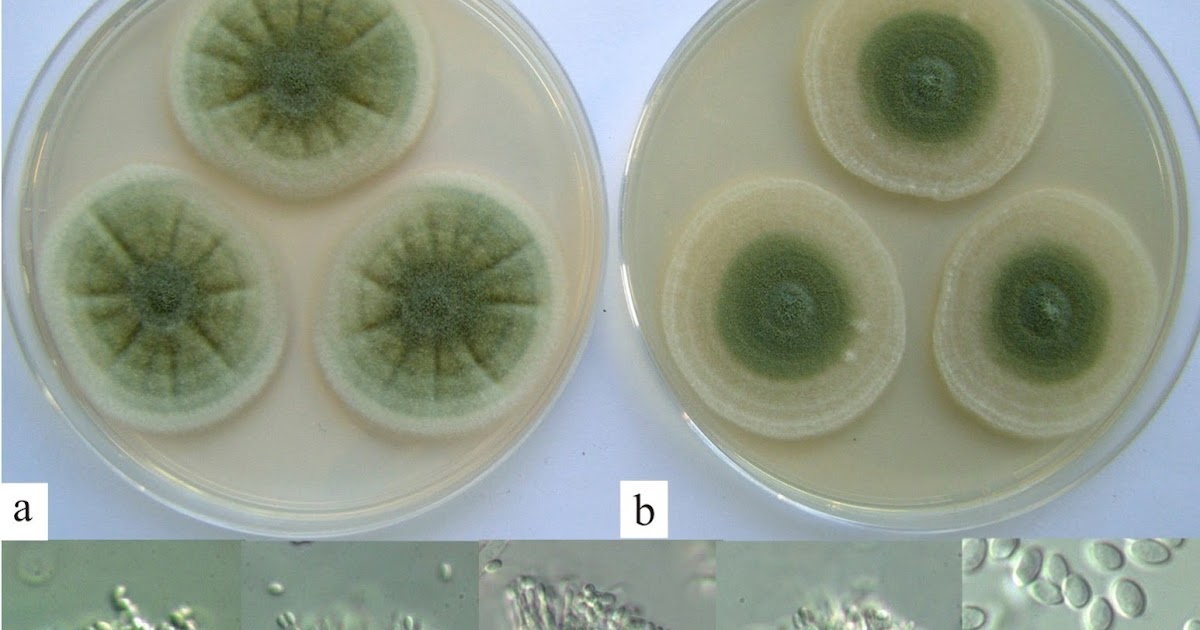

Фото телеоморфы Penicillium thomii

































/https://tf-cmsv2-smithsonianmag-media.s3.amazonaws.com/filer_public/b7/91/b791daa5-f11c-4b05-b2dc-03ed97adc4e8/dec2021_j08_roquefort.jpg)

Раздел: Природная галерея